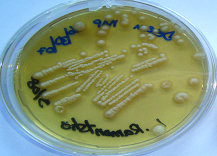

Tinea Capitis: Mixed or Consecutive Infection with White and Violet Strains of Trichophyton violaceum: A Diagnostic or Therapeutic Challenge
Rameshwari Thakur1, Roma Goyal2
1 Associate Professor, Department of Microbiology, Muzaffarnagar Medical College, Meerut Road, Muzaffarnagar, UP, India.
2 Demonstrator, Department of Microbiology, Muzaffarnagar Medical College, Meerut Road, Muzaffarnagar, UP, India.
NAME, ADDRESS, E-MAIL ID OF THE CORRESPONDING AUTHOR: Dr. Rameshwari Thakur, Associate Professor, Department of Microbiology, Muzaffarnagar Medical College, Opposite: Begrajpur Industrial Area, Meerut Road, Muzaffarnagar–251203, UP, India.
E-mail: rameshwari_thakur@hotmail.com
Tinea capitis is a common dermatophyte infection affecting scalp and hair of pre-pubertal children. With introduction of Griseofulvin in 1958, there has been considerable improvement in the treatment of tinea capitis. A seven-year-old male child was brought to the dermatology clinic. He presented with diffuse white scaly patches of alopecia on scalp of one-year duration. The child was sent to the microbiology section of the National Health laboratory, Botswana for the collection of the samples. The samples consisted of scalp scrapings and few plucked hairs from the suspicious areas, which were collected by swab and scalpel blade methods. Potassium hydroxide (10% KOH) mounts were prepared for scales and hair samples. Scales were positive for fungal elements and endothrix type of perforation was seen in hair. Cultures on Sabouraud’s dextrose agar (SDA) and Derm agar were incubated at 25°C, which yielded white variant of Trichophyton violaceum after two weeks of incubation. T. vioaceum (white variant) grew in all the plates. After six weeks of treatment with griseofulvin, the repeat culture grew only T. violaceum (violet strain). The child showed a definite clinical improvement.
Dermatophyte, Endothrix, KOH mount
Case Report
A seven-year-old male child was brought to the dermatologic clinic. The child was brought by his mother with a history of multiple white scaly patches of alopecia on scalp. A provisional diagnosis of tinea capitis was made, and the child was referred to the microbiology section of the National Health Laboratory for the collection of scalp scrapings and hair samples. Collection of samples was done from three different suspicious sites after carefully cleaning the areas with 70% alcohol. The samples were collected by scalpel blade and wet swab methods.
Other members of the family i.e. his mother and a younger sibling a sister, had no complain, but attended the dermatologic clinic for check up and for fungal culture as advised by the dermatologist. Fungal culture was negative.
The child had very short hair and was advised to have head bath with an ordinary shampoo. While collecting the scales from the scalp with the help of a scalpel blade, the scales were allowed to fall directly on to the petri plate and were planted gently in to the medium. Few affected hair were plucked. Both scales and hair samples were examined by KOH mount. Both the samples were positive for fungal elements. The invasion of the hair sample was of endothrix type [Table/Fig-1]. The samples were immediately inoculated on SDA and Dermasel agar and incubated at 25°C.
Fungal culture was positive for T. violaceum (white strain) and growth was obtained after two weeks of incubation. Heavy growth and discrete colonies were seen showing only the white variant in both the plates [Table/Fig-2,3].
Endothrix pattern of hair invasion, with multiple spores present within the hair shaft (“bag of marbles” appearance) (potassium hydroxide 10% mount; Magnification × 400).

T. violaceum (Albino strain) (Wet swab method).
T. violaceum (Albino strain) (Scalpel blade method).

The child was prescribed Griseofulvin for six weeks according to the body weight. He was also advised to have head bath with Ketoconazole shampoo twice a week for six weeks. When the child returned to the dermatology clinic for the follow up, there was substantial improvement in his clinical condition. Another fungal culture examination was requested. This time we again collected samples from three different sites and inoculated on three different plates. To our surprise, the fungal culture was positive for T. violaceum (violet strain). This growth was pure showing only the violet strain [Table/Fig-4].
T. violaceum (violet strain). (Repeat culture after a course of Griseofulvin for 6 weeks).

Another course of Griseofulvin was prescribed for six weeks and was told to continue Ketoconazole shampoo for head bath, and the repeat culture after six weeks was negative.
Discussion
Tinea capitis is a common dermatophyte infection affecting scalp and hair of pre-pubertal children. Quite often, tinea capitis is caused by a single species of dermatophyte. Tinea capitis due to two or more species of fungus causing infection simultaneously is rare [1].
Review of literature done by Muskatblit, described mixed infection and he himself has reported a case of a combined scalp infection with T. schoenleini and T. violaceum [2]. There are other reports describing mixed infection of the scalp with T. schoenleini and T. violaceum [3], Microsporum audounii and M. canis [4] and T. violaceum and T. tonsurans [5].
There are some reports of mixed infections after the introduction of Griseofulvin in 1958 [6–8]. With the introduction of Griseofulvin, T. schoenleinii and M. audouinii, which were responsible for favus, were practically eradicated from Central Europe [9].
T. violaceum is an anthropophilic dermatophyte and cause endothrix type of hair infection. There are few case reports of tinea capitis due to white variant of T. violaceum [10,11]. The author has also reported tinea capitis due to white variants in one of her previous studies [12].
According to Lewis and Hopper, the infection was considered combined or mixed when two or more than two fungi were isolated from the same site. The term ‘consecutive’ was used when a fungal infection due to one pathogen was followed by a second fungal species different from the first. The infection was considered ‘Concurrent’ when the fungal infection was due to two or more different organisms, at different sites and without any causative relation [4,13].
Grover et al., in their recent study from north India on tinea capitis observed mixed pattern of infection both on clinical examination and also on KOH mounts [8]. But, none of the samples grew more than one fungal species. Processing of samples from different suspicious lesions is important in the diagnosis of mixed infections and fungal culture after antifungal treatment is important to confirm the mycological cure. They did not mentioned if fungal culture was done after the course of antifungal therapy for confirming the mycological cure. An efficient teamwork between dermatologist and microbiologist is mandatory for the appropriate diagnosis and follow up.
The commonest species responsible for causing tinea capitis reported by Grover et al., is T. violaceum, which is also the commonest cause of tinea capitis in India [14], Botswana [12], South Africa [15], Nepal [16] and Pakistan [17]. Ours is the first case report where two variants of T. violaceum were isolated from a single case.
In this case their are two possibilities
Possibility1: Here, it appears that in spite of taking three samples from different sites by two different techniques, T. violaceum (violet strain) was possibly missed in the initial collection of the samples. So, the first possibility is that this child had combined (mixed) infection with both the variants of T. violaceum: white and violet, and the violet strain could have been missed during the collection of sample.
Possibility 2: Infection by the violet strain of T. violaceum could have been the consecutive infection while the patient was still on treatment with Griseofulvin.
The carrier state is more common with anthropophilic dermatophyte causing endothrix perforation of hair. When one child from a family is treated for tinea capitis, other family members, whether adults or children should also be screened for tinea capitis or asymptomatic state and should be treated with oral treatment or adjunct therapy as indicated. Hair brush/comb, towels or hair instruments shouldn’t be shared. Also, the bed linen should be adequately laundered. The adults in the family can use selenium disulphide or ketoconazole shampoo twice in a week.
Conclusion
Proper collection of samples and confirming mycological cure is very important for treating a patient of tinea capitis. Appropriate sampling is very important in order to differentiate between combined or consecutive infection.
In resource-limited settings, it is quite challenging to do the follow-up of the patients and screening of family members. Tinea capitis is contagious infection and is of public health infection.
[1]. Rosenthal SA, Fisher D, Urnari D, A localized Outbreak in New York of Tinea capitis Due to Trichophyton violaceum: Observation with special reference to Mixed Infections of scalpAMA Arch Derm 1958 78(6):689-91. [Google Scholar]
[2]. Muskatblit E, Combined Fungous Infections: Report of 6 Cases with a Review of 36 Cases from the LiteratureArch Dermat & Syph 1941 44:631-54. [Google Scholar]
[3]. Tas J, Scabies Norvegica (Report of a Case)Dermatologica 1950 100:148-52. [Google Scholar]
[4]. Loewenthal K, Tinea Capitis Due to Combined Infection with Microsporum audouini and Microsporum lanosum; Report of a CaseArch Dermat & Syph 1948 58:27-33. [Google Scholar]
[5]. Vilanova X, Casanovas M, Double Mycotic Infection in Some Cases of Tinea of the ScalpDermatologica 1954 108:109-13. [Google Scholar]
[6]. Bocobo FC, Eadie GA, Miedler LJ, Epidemiologic study of Tinea capitis caused by T. tonsurans and M. audouiniiPublic Health Reports 1965 80(10):891-98. [Google Scholar]
[7]. Sidat MM, Correia D, Buene TP, Tinea capitis among rural school children of the district of Magude, in Maputo province, MozambiqueMycosis 2006 49:480-83. [Google Scholar]
[8]. Grover C, Arora P, Manchanda V, Tinea capitis in the pediatric population: A study from North IndiaIndian J Dermatol Venereol Leprol 2010 76:527-32. [Google Scholar]
[9]. Seebacher C, Bouchara JP, Mignon B, Updates on the epidemiology of Dermatophyte infectionsMycopathol 2008 166(5-6):335-52. [Google Scholar]
[10]. Woldeamanuel Y, Leekassa R, Petrini B, Chyssanthou E, White variants of Trichophyton violaceum isolated in EthiopiaActa Pathologica, Microbiologica et Immunologica Scandinavica 2005 113:708-12. [Google Scholar]
[11]. Valari M, Stathi A, Petropoulou T, Kakourou T, Pangali A, Arabatzis M, Cases of Tinea capitis due to pale isolates of Trichophyton violaceum (Trichophyton glabrum) in South-East Europe. A challenge to the clinical laboratoryMedical Mycology Case Reports 2012 1(1):66-68. [Google Scholar]
[12]. Thakur R, Tinea capitis in BotswanaClin Cosmet Investig Dermatol 2013 3(6):37-41. [Google Scholar]
[13]. Lewis GM, Hopper ME, Concurrent, combined and consecutive fugous infections of the skin cultural ExperienceArch Dermat & Syph 1943 47:27 [Google Scholar]
[14]. Kalla G, Begra B, Solanki A, Goyal A, Batra A, Clinico mycological study of Tinea capitis in Desert District of RajasthanInd J Dermatol leprol 1995 61:342-45. [Google Scholar]
[15]. Morar N, Derm FC, Dlova NC, Gupta AK, Aboobaker J, Tinea Capitis in Kwa-Zulu Natal, South AfricaPaed Dermatol 2004 21(4):444-47. [Google Scholar]
[16]. Jha BN, Garg VK, Aggarwal S, Khanal B, Aggarwalla A, Tinea capitis in Eastern NepalInt J Dematol 2006 45:100-2. [Google Scholar]
[17]. Hussain I, Aman S, Haroon TS, Jahangir M, Nagi AH, Tinea capitis in Lahore, PakistanInt J Dermatol 1994 33:255-57. [Google Scholar]